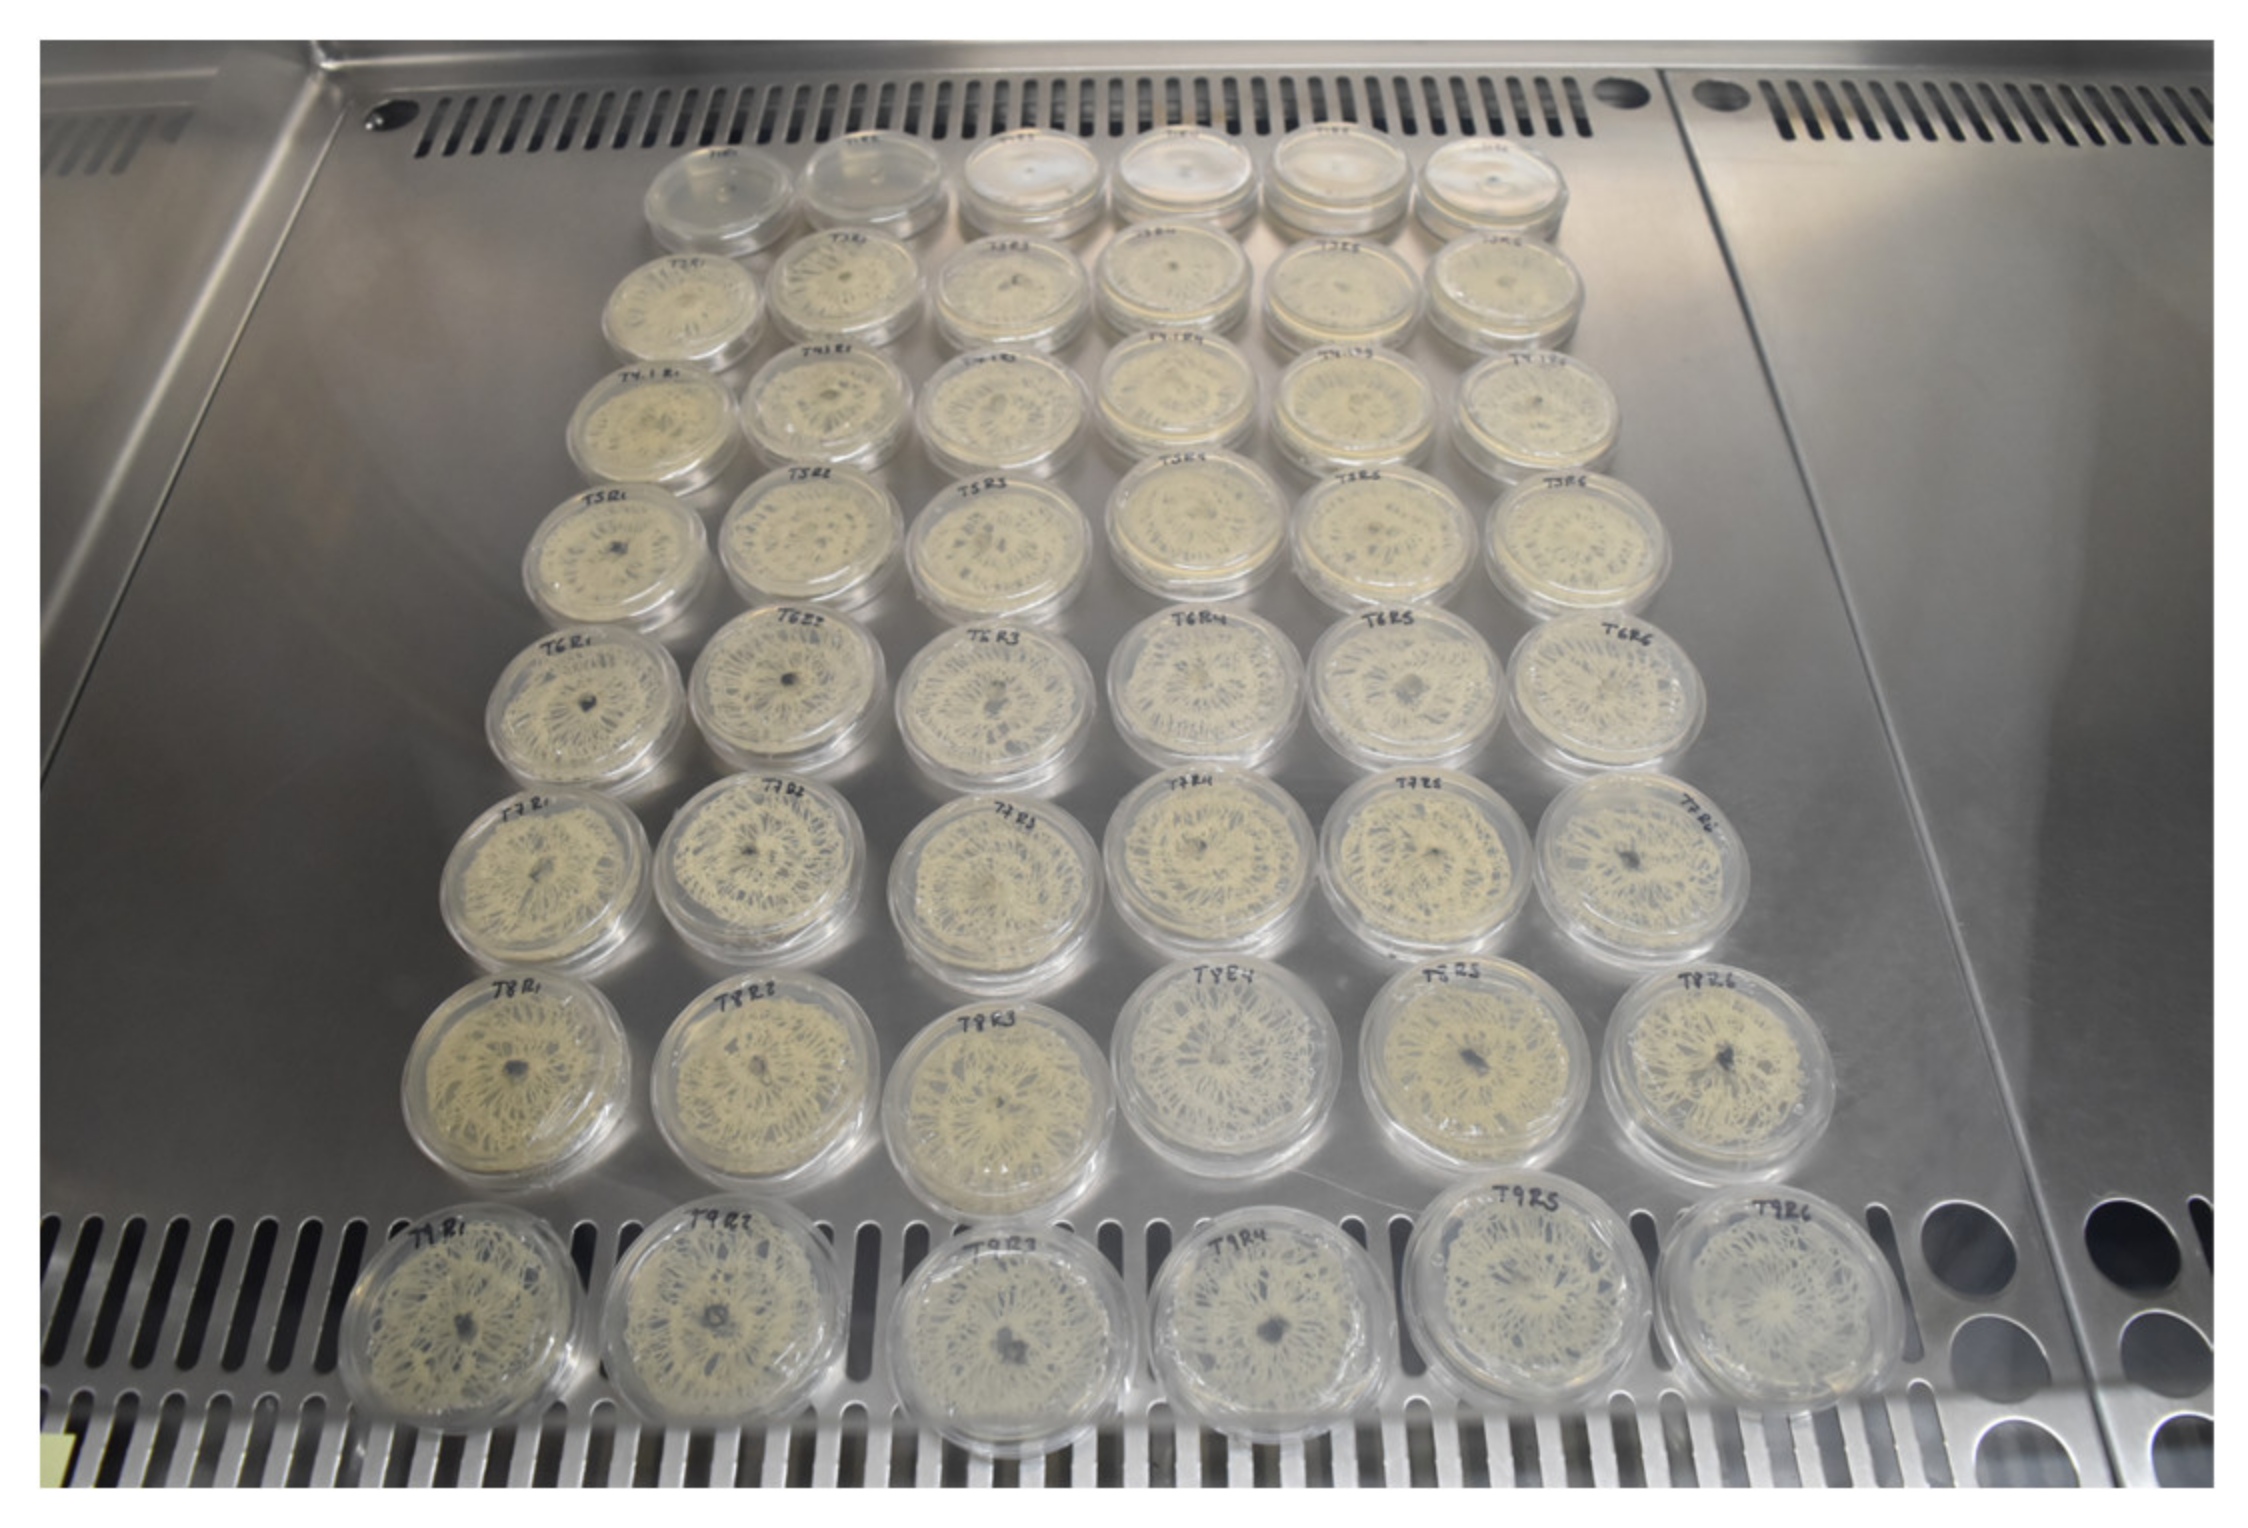

Anthracnose Disease Control and Postharvest Quality of Hass Avocado Stored in Biobased PLA/PBAT/Pine Essential Oil/Chitosan Active Packaging Nets
Abstract
:1. Introduction
2. Results and Discussion
3. Materials and Methods
3.1. Materials and Manufacturing of Nets
3.2. Chemical Characterization of the Pine Essential Oils Using GC-MS
3.3. Fungicidal Activity on Hass Avocados
3.3.1. Fungal Isolates
3.3.2. In Vitro Studies
Evaluation of Mycelial Growth, Inhibition Index, and Spore Germination
3.3.3. In Situ Studies
Treatment Application
Disease Incidence and Severity Index of Hass Avocados
3.4. Quality and Ripening of Hass Avocados
Weight Loss, Firmness, TSS, Dry Matter, Color, and CO2 Production
3.5. Statistical Analysis
4. Conclusions
Author Contributions
Funding
Informed Consent Statement
Data Availability Statement
Acknowledgments
Conflicts of Interest
References
- Araújo, R.G.; Rodriguez-Jasso, R.M.; Ruiz, H.A.; Pintado, M.M.E.; Aguilar, C.N. Avocado by-products: Nutritional and functional properties. Trends Food Sci. Technol. 2018, 80, 51–60. [Google Scholar] [CrossRef]
- Tamayo, M.P.J. Enfermedades del aguacate. Rev. Politécnica 2007, 3, 51–70. Available online: https://revistas.elpoli.edu.co/index.php/pol/article/view/62#:~:text=Las%20enfermedades%20de%20mayor%20importancia,normalmente%20ameritan%20decisiones%20de%20manejo (accessed on 5 August 2022).
- Bautista-Baños, S.; Ventura-Aguilar, R.I.; Ramos-García, M.; de Avocado, L. Postharvest Pathology of Fresh Horticultural Produce; Palou, L., Smilanick, J.I., Pareek, S., Eds.; CRC: Boca Raton, FL, USA, 2020; pp. 227–256. [Google Scholar]
- Herrera-González, J.A.; Bautista-Baños, S.; Salazar-García, S.; Gutiérrez-Martínez, P. Current situation of postharvest handling and fungal diseases of avocado ‘Hass’ for export in Michoacán, Mexico. Rev. Mex. Cienc. Agríc. 2020, 11, 1647–1660. Available online: https://www.scielo.org.mx/pdf/remexca/v11n7/2007-0934-remexca-11-07-1647-en.pdf (accessed on 5 August 2022).
- Rives-Castillo, S.C.H.; Bautista-Baños, S.; Correa-Pacheco, Z.N.; Ventura-Aguilar, R.I. Situación actual de los envases utilizados para la conservación postcosecha de productos hortofrutícolas. Rev. Iberoam. Tecnol. Postcosecha 2020, 21, 17–34. Available online: http://www.redalyc.org/articulo.oa?id=81363356002 (accessed on 5 August 2022).
- Kargarzadeh, H.; Huang, J.; Lin, N.; Ahmad, I.; Mariano, M.; Dufresne, A.; Dufresne, A.; Thomas, S.; Gałęski, A. Recent developments in nanocellulose-based biodegradable polymers, thermoplastic polymers, and porous nanocomposites. Prog. Polym. Sci. 2018, 87, 197–227. [Google Scholar] [CrossRef]
- Long, J.M.; Wolcott, P.; Zhang, J. Study of biodegradable polylactide/poly(butylene adipate-co-terephthalate) blends. Biomacromolecules 2006, 7, 199–207. [Google Scholar] [CrossRef]
- Rodríguez, P.T.; Ramírez, A.M.A.; Rivero-González, D.; Bosquez, M.E.; Barrera, N.L.L.; Bautista, B.S. Propiedades químico-estructurales y actividad biológica de la quitosana en microorganismos fitopatógenos. Rev. Chapingo. Ser. Hortic. 2009, 15, 307–317. Available online: http://www.scielo.org.mx/scielo.php?script=sci_arttext&pid=S1027-152X2009000500012 (accessed on 5 August 2022).
- Romanazzi, G.; Feliziani, E.; Bautista-Baños, S.; Sivakumar, D. Shelf life extension of fresh fruit and vegetables by chitosan. Crit. Rev. Food Sci. Nutr. 2017, 57, 579–601. [Google Scholar] [CrossRef]
- Bautista-Baños, S.; Correa-Pacheco, Z.N.; Black-Solís, J.D. Current status of the effectiveness of essential oils for controlling phytopathogenic fungi, a review. Acta Agríc. Pecu. 2020, 6, E0061008. [Google Scholar] [CrossRef]
- Chao, S.C.; Young, D.G.; Oberg, C.J. Screening for inhibitory activity of essential oils on selected bacteria, fungi and viruses. J. Essent. Oil Res. 2000, 12, 639–649. [Google Scholar] [CrossRef]
- Krauze-Baranowska, M.; Mardarowicz, M.; Wiwart, M.; Pobłocka, L.; Dynowska, M. Antifungal activity of the essential oils from some species of the genus Pinus. Z. Für Nat. C 2002, 57, 478–482. [Google Scholar] [CrossRef] [PubMed]
- Motiejūnaitė, O.; Pečiulytė, D. Fungicidal properties of Pinus sylvestris L. for improvement of air quality. Medicina 2004, 40, 787–794. Available online: https://pubmed.ncbi.nlm.nih.gov/15300001/ (accessed on 5 August 2022). [PubMed]
- Amri, I.; Hanana, M.; Gargouri, S.; Jamoussi, B.; Hamrouni, L. Comparative study of two coniferous species (Pinus pinaster Aiton and Cupressus sempervirens L. var. dupreziana [A. Camus] Silba) essential oils: Chemical composition and biological activity. Chil. J. Agric. Res. 2013, 73, 259–266. [Google Scholar] [CrossRef]
- Rodrigues, A.M.; Mendes, M.D.; Lima, A.S.; Barbosa, P.M.; Ascensão, L.; Barroso, J.G.; Pedro, L.G.; Mota, M.M.; Figueiredo, A.C. Pinus halepensis, Pinus pinaster, Pinus pinea and Pinus sylvestris essential oils chemotypes and monoterpene hydrocarbon enantiomers, before and after inoculation with the pinewood nematode Bursaphelenchus xylophilus. Chem. Biodivers. 2017, 14, e1600153. [Google Scholar] [CrossRef] [PubMed]
- Mitić, Z.S.; Jovanović, B.; Jovanović, S.Č.; Mihajilov-Krstev, T.; Stojanović-Radić, Z.Z.; Cvetković, V.J.; Mitrovic, T.L.; Marin, P.D.; Zlatkovic, B.K.; Stojanović, G.S. Comparative study of the essential oils of four Pinus species: Chemical composition, antimicrobial and insect larvicidal activity. Ind. Crops Prod. 2018, 111, 55–62. [Google Scholar] [CrossRef]
- Segura-Palacios, M.A.; Correa-Pacheco, Z.N.; Corona-Rangel, M.L.; Martinez-Ramirez, O.C.; Salazar-Piña, D.A.; Ramos-García, M.d.L.; Bautista-Baños, S. Use of natural products on the control of Aspergillus flavus and production of aflatoxins in vitro and on tomato fruit. Plants 2021, 10, 2553. [Google Scholar] [CrossRef]
- Ventura-Aguilar, R.I.; Gónzalez-Andrade, C.; Hernández-López, M.; Correa-Pacheco, Z.N.; Teksür, P.K.; Ramos-García, M.d.L.; Bautista-Baños, S. Effect of biodegradable coatings on the growth of Aspergillus flavus in vitro, on maize grains, and on the quality of tortillas during storage. Molecules 2022, 27, 4545. [Google Scholar] [CrossRef] [PubMed]
- Restuccia, D.; Spizzirri, U.G.; Parisi, O.I.; Cirillo, G.; Curcio, M.; Iemma, F.; Puoci, F.; Vinci, G.; Picci, N. New EU regulation aspects and global market of active and intelligent packaging for food industry applications. Food Control 2010, 21, 1425–1435. [Google Scholar] [CrossRef]
- Castellano, S.; Mugnozza, G.; Russo, G.; Briassoulis, D.; Mistriotis, A.; Hemming, S.; Waaijenberg, D. Plastic nets in agriculture: A general review of types and applications. Appl. Eng. Agric. 2008, 24, 799–808. Available online: https://pubag.nal.usda.gov/catalog/748777 (accessed on 5 August 2022). [CrossRef]
- Black-Solis, J.; Ventura-Aguilar, R.I.; Correa-Pacheco, Z.; Corona-Rangel, M.A.; Bautista-Baños, S. Preharvest use of biodegradable polyester nets added with cinnamon essential oil and the effect on the storage life of tomatoes and the development of Alternaria alternata. Sci. Hortic. 2019, 245, 65–73. [Google Scholar] [CrossRef]
- Sjödin, K.; Persson, M.; Fäldt, J.; Ekberg, I.; Borg-Karlson, A.-K. Occurrence and correlations of monoterpene hydrocarbon enantiomers in Pinus sylvestris and Picea abies. J. Chem. Ecol. 2000, 26, 1701–1720. Available online: https://link.springer.com/article/10.1023/A:1005547131427 (accessed on 5 August 2022). [CrossRef]
- Nikolić, B.; Ristić, M.; Bojović, S.; Matevski, V.; Krivošej, Z.; Marin, P.D. Essential-oil composition of the needles collected from natural populations of Macedonian pine (Pinus peuce Griseb.) from the Scardo-Pindic mountain system. Chem. Biodivers. 2014, 11, 934–948. [Google Scholar] [CrossRef] [PubMed]
- Tullio, V.; Nostro, A.; Mandras, N.; Dugo, P.; Banche, G.; Cannatelli, M.A.; Cuffini, A.M.; Alonzo, V.; Carlone, N.A. Antifungal activity of essential oils against filamentous fungi determined by broth microdilution and vapour contact methods. J. Appl. Microbiol. 2007, 102, 1544–1550. [Google Scholar] [CrossRef] [PubMed]
- Herrera-González, J.A.; Bautista-Baños, S.; Serrano, M.; Romanazzi, G.; Gutiérrez-Martínez, P. Non-chemical treatments for the pre and post-harvest elicitation of defense mechanisms in the fungi–avocado pathosystem. Molecules 2021, 26, 6819. [Google Scholar] [CrossRef] [PubMed]
- Zhang, R.; Lan, W.; Ding, J.; Ahmed, S.; Qin, W.; He, L.; Liu, Y. Effect of PLA/PBAT antibacterial film on storage quality of passion fruit during the shelf-life. Molecules 2019, 24, 3378. [Google Scholar] [CrossRef]
- Zauberman, G.; Jobin, M. Avocado (Persea americana Mill.) quality changes in response to low temperature storage. Postharv. Biol. Technol. 1995, 5, 235–243. [Google Scholar] [CrossRef]
- Márquez, C.; Yepes, D.; Sanchez, L.; Osorio, J.C.; Yepes, D.; Sanchez, L.; Osorio, J. Cambios físico-químicos del aguacate (persea americana mill. cv. “hass”) en poscosecha para dos municipios de antioquia. Temas Agrar. 2014, 19, 32–47. [Google Scholar] [CrossRef]
- Cox, K.A.; McGhie, T.K.; White, A.; Woolf, A.B. Skin colour and pigment changes during ripening of ‘Hass’ avocado fruit. Postharv. Biol. Technol. 2004, 31, 287–294. [Google Scholar] [CrossRef]
- Herrera-González, J.A.; Salazar-García, S.; Martínez-Flores, H.E.; Ruiz-García, J.E. Indicadores preliminares de madurez fisiológica y comportamiento postcosecha del fruto de aguacate Méndez. Rev. Fitotec. Mex. 2017, 40, 55–63. Available online: https://www.redalyc.org/articulo.oa?id=61051194007 (accessed on 5 August 2022). [CrossRef]
- Astudillo-Ordóñez, C.E.; Rodríguez, P. Physicochemical parameters of avocado Persea americana Mill. cv. Hass (Lauraceae) grown in Antioquia (Colombia) for export. Corpoica Cienc. Technol. Agropecu. 2018, 19, 383–392. [Google Scholar] [CrossRef]
- Rodríguez, P.; Henao, J.C.; Correa, G.; Aristizabal, A. Identification of harvest maturity indicators for ‘Hass’ avocado adaptable to field conditions. HortTechnology 2018, 28, 815–821. [Google Scholar] [CrossRef]
- Hernández-López, M.; Correa-Pacheco, Z.N.; Bautista-Baños, S.; Zavaleta-Avejar, L.; Benítez-Jiménez, J.J.; Sabino-Gutiérrez, M.A.; Ortega-Gudiño, P. Bio-based composite fibers from pine essential oil and PLA/PBAT polymer blend. Morphological, physicochemical, thermal and mechanical characterization. Mater. Chem. Phys. 2019, 234, 345–353. [Google Scholar] [CrossRef]
- Black-Solis, J.; Ventura-Aguilar, R.I.; Barrera-Necha, L.L.; Bautista-Baños, S. Chemical characterization, compositional variability and mathematical modelling of the effect of essential oils in Alternaria alternata. Rev. Mex. Fitopatol. 2017, 35, 204–226. [Google Scholar] [CrossRef]
- Secretaria de Economía. Productos Alimenticios no Industrializados para Uso Humano-Fruta-Fresca-Aguacate (Persea americana Mill.). Especificaciones. (Cancela a la NMX-FF-016-SFCI-2006). 2006. Available online: https://media.gotomexico.today/reglament/nmx-ff-016-scfi-2016.pdf (accessed on 5 August 2022).
- Burnett, H.L.; Hunter, B.B. Illustrated Genera of Imperfect Fungi, 3rd ed.; Burgess Publishing Co.: Minneapolis, MN, USA, 1972; p. 241. [Google Scholar]
- Ventura-Aguilar, R.I.; Bautista-Baños, S.; Flores-García, G.; Zavaleta-Avejar, L. Impact of chitosan based edible coatings functionalized with natural compounds on Colletotrichum fragariae development and the quality of strawberries. Food Chem. 2018, 262, 142–149. [Google Scholar] [CrossRef]
- AOAC. Official Methods of Analysis AOAC International; AOAC: Washington, DC, USA, 1990. [Google Scholar]
- AOAC. Association of Official Analytical Chemists 934.1. Loss on drying (Moisture); AOAC: Gaithersburg, MD, USA, 1999. [Google Scholar]

| Compound Identified | Retention Time (min) |
|---|---|
| 1.-(R) α pinene | 6.335 |
| 2.-Camphene | 6.623 |
| 3.-1,4-Cieneole | 8.142 |
| 4.-p-Cimene | 8.322 |
| 5.-Eucalyptol | 8.538 |
| 6.-c–Terpinene | 9.307 |
| 7.-Terpinolene | 10.099 |
| 8.-Fenchol | 10.604 |
| 9.-α-Terpineol | 11.146 |
| 10.-b-terpineol | 11.364 |
| 11.-endo-Borneol | 11.952 |
| 12.-Terpineol | 12.595 |
| 13.-Isoterpinolene | 12.794 |
| Treatments | Colletotrichum gloeosporioides | Rhizopus stolonifer | ||
|---|---|---|---|---|
| Mycelial Growth (cm) | Growth Inhibition (%) | Mycelial Growth (mm) | Growth Inhibition (%) | |
| T1 | 53.0 ± 0 a | 0.0 | 53.0 ± 0 a | 0.0 |
| T2 | 53.0 ± 0 a | 0.0 | 53.0 ± 0 a | 0.0 |
| T3 | 51.5 ± 2.4 ab | 2.8 | 53.0 ± 0 a | 0.0 |
| T4 | 48.2 ± 1.3 ab | 9.0 | 53.0 ± 0 a | 0.0 |
| T5 | 52.0 ± 2.3 a | 1.8 | 53.0 ± 0 a | 0.0 |
| T6 | 52.0 ± 2.3 a | 1.8 | 53.0 ± 0 a | 0.0 |
| T7 | 46.0 ± 2.1 b | 12.3 | 53.0 ± 0 a | 0.0 |
| T8 | 43.1 ± 2.2 c | 19.0 | 53.0 ± 0 a | 0.0 |
| Treatments | Weight Loss (%) | Firmness (N) | TSS (°Brix) | Dry Matter (%) | Color (ΔE) | CO2 Production (mg CO2 kg−1 h−1) | |
|---|---|---|---|---|---|---|---|
| Epidermis | Mesocarp | ||||||
| C1 | 22.5 a | 21.3 b | 7.8 a | 21.7 a | 4.4 a | 11.8 ab | 41.1 c |
| C2 | 23.6 a | 20.5 b | 7.1 a | 23.2 a | 5.3 a | 9.8 a | 41.1 c |
| T2 | 23.4 a | 14.6 a | 8.1 a | 24.3 a | 8.3 b | 9.9 a | 38.0 a |
| T4 | 23.8 a | 35.9 c | 7.5 a | 24.4 a | 5.9 a | 10.8 ab | 42.0 c |
| T5 | 23.6 a | 39.6 c | 7.5 a | 24.6 a | 9.8 b | 13.1 ab | 40.1 b |
| T8 | 23.0 a | 39.0 c | 7.7 a | 23.5 a | 9.8 b | 15.5 b | 42.0 c |
| Treatments | Net Composition |
|---|---|
| T1 | Control (PDA) |
| T2 | 60/40 PLA/PBAT |
| T3 | 60/40 PLA/PBAT + 10 % PEO |
| T4 | 60/40 PLA/PBAT + 12 % PEO |
| T5 | 60/40 PLA/PBAT + 1% CH |
| T6 | 60/40 PLA/PBAT + 10 % PEO + 1% CH |
| T7 | 60/40 PLA/PBAT + 14 % PEO + 1% CH |
| T8 | 60/40 PLA/PBAT + 20 % PEO + 1% CH |
Publisher’s Note: MDPI stays neutral with regard to jurisdictional claims in published maps and institutional affiliations. |
© 2022 by the authors. Licensee MDPI, Basel, Switzerland. This article is an open access article distributed under the terms and conditions of the Creative Commons Attribution (CC BY) license (https://creativecommons.org/licenses/by/4.0/).
Share and Cite
Correa-Pacheco, Z.N.; Ventura-Aguilar, R.I.; Zavaleta-Avejar, L.; Barrera-Necha, L.L.; Hernández-López, M.; Bautista-Baños, S. Anthracnose Disease Control and Postharvest Quality of Hass Avocado Stored in Biobased PLA/PBAT/Pine Essential Oil/Chitosan Active Packaging Nets. Plants 2022, 11, 2278. https://doi.org/10.3390/plants11172278
Correa-Pacheco ZN, Ventura-Aguilar RI, Zavaleta-Avejar L, Barrera-Necha LL, Hernández-López M, Bautista-Baños S. Anthracnose Disease Control and Postharvest Quality of Hass Avocado Stored in Biobased PLA/PBAT/Pine Essential Oil/Chitosan Active Packaging Nets. Plants. 2022; 11(17):2278. https://doi.org/10.3390/plants11172278
Chicago/Turabian StyleCorrea-Pacheco, Zormy N., Rosa I. Ventura-Aguilar, Leonor Zavaleta-Avejar, Laura L. Barrera-Necha, Mónica Hernández-López, and Silvia Bautista-Baños. 2022. "Anthracnose Disease Control and Postharvest Quality of Hass Avocado Stored in Biobased PLA/PBAT/Pine Essential Oil/Chitosan Active Packaging Nets" Plants 11, no. 17: 2278. https://doi.org/10.3390/plants11172278
APA StyleCorrea-Pacheco, Z. N., Ventura-Aguilar, R. I., Zavaleta-Avejar, L., Barrera-Necha, L. L., Hernández-López, M., & Bautista-Baños, S. (2022). Anthracnose Disease Control and Postharvest Quality of Hass Avocado Stored in Biobased PLA/PBAT/Pine Essential Oil/Chitosan Active Packaging Nets. Plants, 11(17), 2278. https://doi.org/10.3390/plants11172278

